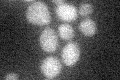
YLR389C
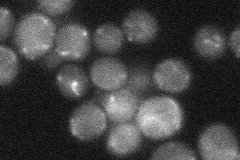
YLR389C
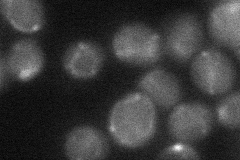
YLR389C
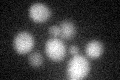
YLR389C
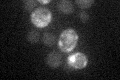
YLR389C

View description
Metalloprotease involved, with homolog Axl1p, in N-terminal processing of pro-a-factor to the mature form; member of the insulin-degrading enzyme family
Localization:
Intensity:
Fold change:
Significance:
-
C’ GFP library in SD
below threshold16.42 -
N' NOP1pr-GFP in SD

punctate,mitochondria127.877 -
N' TEF2pr-mCherry in SD

punctate,mitochondria147.995 -
N' NATIVEpr-GFP in SD
punctate,mitochondria26.1284 -
N' TEF2pr-VC and Cyto-VN in SD
punctate35.2635 -
C’ GFP library in SD+DTT
cytosol15.140.92No -
C’ GFP library in SD+H2O2

cytosol18.481.12No -
C’ GFP library in Starvation Media
cytosol16.681.01No -
C’ GFP library on the background of Pup2-DaMP

below threshold -
C’ GFP library on the background of CCT mutant

below threshold17.3261.05474No
